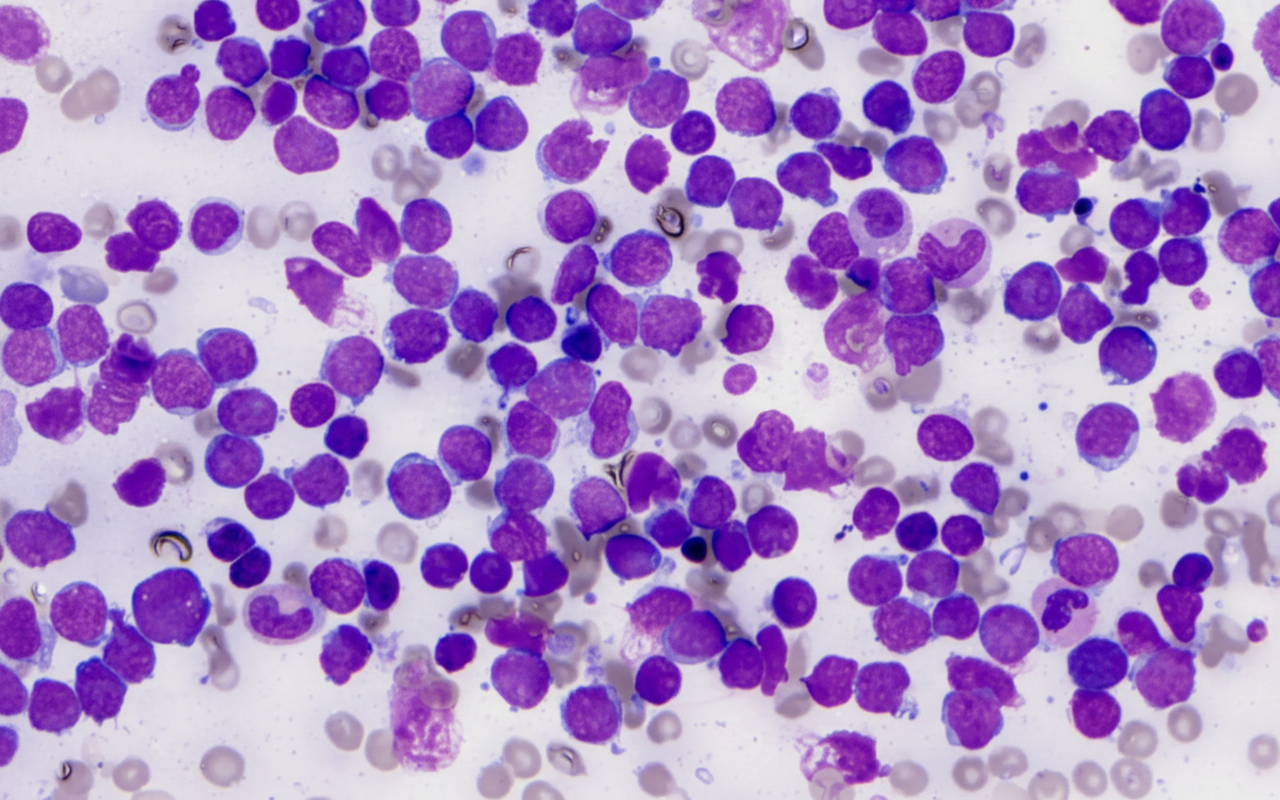
Image for question 48

Which of the following is not a component of the triad of Wilm's tumor?
Which of the following findings is true about ALL?
What is the commonest site of metastasis for Wilms' tumor?
What is the best prognostic factor for a 2-year-old child diagnosed with Acute Lymphoblastic Leukemia (ALL)?
Which of the following malignancies in children does not typically require immediate treatment?
An 8-year-old child is diagnosed with Langerhans cell histiocytosis with bone involvement. All of the following are true about Langerhans cell histiocytosis, EXCEPT:
A 7-year-old boy presents with a week-long history of severe headache. Physical examination reveals tenderness on palpation of long bones, hepatosplenomegaly, and generalized lymphadenopathy, along with petechial hemorrhages on the skin. Laboratory findings include hemoglobin 8.8 g/dL, hematocrit 26.5%, platelet count 34,700/mm3, and WBC count 14,800/mm3. A bone marrow biopsy shows 100% cellularity, with near-complete replacement by large cells characterized by scant, agranular cytoplasm, delicate nuclear chromatin, and rare nucleoli. Chemotherapy is anticipated to induce a complete remission. Which of the following combinations of phenotypic and karyotypic markers is most likely to be present in the marrow cells of this boy?
A 7-year-old child presents with fever, bleeding gums, and fatigue for 4 days. On examination, she has splenomegaly. CBC shows Hb of 6 gm%, TLC 75,000/µL, and platelet count of 35,000/µL. Bone marrow aspiration shows these cells comprising 50% of marrow cells. What is the diagnosis?
A 4-year-old female is being evaluated for the sudden onset of multiple petechiae and bruises. She is found to have a peripheral leukocyte count of 55,000, 86% of which are small, homogeneous cells that have nuclei with immature chromatin. Indistinct nucleoli are also present. Initial tests on these immature cells are as follows: TdT, positive; PAS, positive; acid phosphatase, positive; and myeloperoxidase, negative. Based on these findings, the immature cells most likely originated from?
A 7-year-old boy presents with a left renal mass, bone pain, and radiographically confirmed bone metastatic deposits. What is the most likely renal tumor?
Explanation: **Explanation:** Wilms’ tumor (Nephroblastoma) is the most common primary renal malignancy in children. The classic clinical presentation is characterized by a specific **triad of symptoms**: 1. **Abdominal Mass:** The most common presenting feature (found in >90% of cases). It is typically large, smooth, firm, and rarely crosses the midline. 2. **Abdominal Pain:** Present in approximately 30–40% of patients, often due to rapid tumor expansion or subcapsular hemorrhage. 3. **Hematuria:** Seen in about 25% of cases (usually microscopic), resulting from tumor invasion into the renal pelvis. **Why Fever is the correct answer:** While fever can occur in Wilms’ tumor (often due to tumor necrosis or associated urinary tract infections), it is **not** considered a component of the classic diagnostic triad. Fever is a non-specific systemic symptom rather than a hallmark clinical sign of the disease. **Analysis of Incorrect Options:** * **Abdominal Mass (B):** This is the hallmark of Wilms’ tumor. It is usually discovered incidentally by parents while bathing or dressing the child. * **Hematuria (A) and Pain (D):** These complete the triad. Their presence alongside a flank mass strongly suggests a renal origin. **High-Yield Clinical Pearls for NEET-PG:** * **Hypertension:** Present in 25% of cases due to increased Renin production (Goldblatt kidney mechanism). * **WAGR Syndrome:** Wilms’ tumor, Aniridia, Genitourinary anomalies, and intellectual disability (Range of mental retardation). Associated with **WT1 gene** deletion on chromosome 11p13. * **Beckwith-Wiedemann Syndrome:** Associated with **WT2 gene** (11p15), macroglossia, hemihypertrophy, and omphalocele. * **Management Tip:** Avoid vigorous palpation of the abdomen to prevent rupture of the tumor capsule and subsequent peritoneal seeding.
Explanation: **Explanation:** Acute Lymphoblastic Leukemia (ALL) is the most common pediatric malignancy, characterized by the uncontrolled proliferation of immature lymphoid cells (blasts) in the bone marrow. **1. Why "All of the Above" is correct:** The clinical presentation of ALL is primarily driven by **bone marrow failure** due to the overcrowding of normal hematopoietic stem cells by leukemic blasts. This leads to: * **Anemia (Option A):** Reduced red blood cell production results in pallor, fatigue, and lethargy. This is a hallmark finding in over 80% of cases. * **Leukopenia (Option B):** While the total WBC count can be high (due to circulating blasts), there is a functional **neutropenia** (low mature white cells), making patients prone to infections and fever. * **Hepatomegaly (Option C):** Leukemic cells frequently infiltrate extramedullary sites. Hepatosplenomegaly and generalized lymphadenopathy are common physical findings due to this systemic infiltration. **2. Clinical Pearls for NEET-PG:** * **Thrombocytopenia:** Also a common feature, leading to petechiae, purpura, and epistaxis. * **Bone Pain:** Occurs in 25% of cases due to marrow expansion; it can often mimic juvenile idiopathic arthritis. * **Diagnosis:** Bone marrow aspiration showing **>20% blasts** is the gold standard. * **Morphology:** L1 (small, uniform blasts) is the most common FAB subtype in children; L3 (Burkitt-type) has the worst prognosis. * **Prognostic Factors:** Age (1–9 years) and low initial WBC count (<50,000/µL) are favorable indicators. The presence of the **t(12;21) translocation** (TEL-AML1) carries a good prognosis, whereas **t(9;22)** (Philadelphia chromosome) carries a poor prognosis.
Explanation: **Explanation:** Wilms' tumor (Nephroblastoma) is the most common primary renal malignancy in children. The correct answer is **Lungs** because Wilms' tumor primarily spreads via the **hematogenous route**. Once the tumor cells enter the renal vein and the inferior vena cava, the first major capillary bed they encounter is in the pulmonary circulation, making the lungs the most frequent site of distant metastasis (seen in approximately 10-15% of patients at diagnosis). **Analysis of Options:** * **Lungs (Correct):** The primary site of distant spread. Pulmonary metastases typically appear as "cannonball" lesions on imaging. * **Liver:** This is the second most common site of distant metastasis. It occurs via hematogenous spread or direct extension. * **Bones & Brain:** These are **extremely rare** sites for classic Wilms' tumor. If a pediatric renal tumor metastasizes to the bone, clinicians should strongly suspect **Clear Cell Sarcoma of the Kidney (CCSK)**, often nicknamed the "Bone-metastasizing renal tumor." If it spreads to the brain, **Rhabdoid Tumor of the Kidney** is a more likely diagnosis. **High-Yield NEET-PG Pearls:** 1. **Staging:** Unlike many other tumors, Wilms' staging is based on both surgical and pathological findings. 2. **WAGR Syndrome:** Associated with *WT1* gene deletion (Wilms tumor, Aniridia, Genitourinary anomalies, and intellectual disability/Retardation). 3. **Beckwith-Wiedemann Syndrome:** Associated with *WT2* gene; presents with macroglossia, omphalocele, and hemihypertrophy. 4. **Clinical Presentation:** Most commonly presents as a painless, smooth abdominal mass that **does not cross the midline** (unlike Neuroblastoma).
Explanation: In Pediatric Acute Lymphoblastic Leukemia (ALL), the two most important clinical predictors of prognosis are **Age** and **Initial White Blood Cell (WBC) count**. **Explanation of the Correct Option:** * **Age between 1 and 10 years:** This is the "favorable age group." Children diagnosed within this window have significantly higher cure rates (exceeding 90%) compared to infants (<1 year) or adolescents (>10 years), who often present with more aggressive biological subtypes. **Explanation of Incorrect Options:** * **TLC > 1 lac (100,000/mm³):** This is a **poor** prognostic factor. A high tumor burden at presentation (TLC > 50,000/mm³) indicates a higher risk of relapse and central nervous system involvement. * **Presence of petechiae:** This is a clinical sign of thrombocytopenia, which is a common presenting feature of ALL. It does not serve as an independent prognostic marker for long-term survival. * **Translocation t(9:22):** Also known as the **Philadelphia chromosome**, this is a **very poor** prognostic factor. It is associated with resistance to standard chemotherapy and requires targeted therapy (e.g., Imatinib). **High-Yield Clinical Pearls for NEET-PG:** * **Best Prognostic Factors:** Age 1–10 years, TLC < 50,000/mm³, Hyperdiploidy (>50 chromosomes), and the presence of **t(12;21)** (TEL-AML1). * **Worst Prognostic Factors:** Age <1 or >10 years, TLC > 50,000/mm³, Hypodiploidy, and **t(9;22)** or **t(4;11)**. * **Most Important Response Marker:** Minimal Residual Disease (MRD) at the end of induction therapy is currently the strongest predictor of overall outcome.
Explanation: ### **Explanation** The correct answer is **Neuroblastoma (Option A)**. #### **Why Neuroblastoma is the Correct Answer** In pediatric oncology, certain cases of Neuroblastoma—specifically **Stage 4S (Special)**—are unique because they can undergo **spontaneous regression** without any aggressive intervention. Stage 4S occurs in infants (<12 months) where the tumor is localized but has spread limited to the liver, skin, and/or bone marrow (less than 10% involvement). Because these tumors often differentiate into benign forms or disappear on their own, a "watch and wait" approach is frequently adopted unless life-threatening symptoms (like respiratory distress from hepatomegaly) occur. #### **Why Other Options are Incorrect** * **Burkitt’s Lymphoma (Option B):** This is one of the fastest-growing human tumors with a doubling time of ~24 hours. It carries a massive risk of **Tumor Lysis Syndrome (TLS)** and requires immediate stabilization and chemotherapy. * **T-cell Lymphoblastic Leukemia (Option C):** Often presents with a large mediastinal mass, leading to **Superior Vena Cava (SVC) syndrome** or airway obstruction. It is a medical emergency requiring prompt treatment. * **Acute Myeloid Leukemia (AML) (Option D):** AML is associated with severe cytopenias, life-threatening infections, and coagulopathies (especially DIC in the M3 subtype). Immediate induction therapy is mandatory. #### **High-Yield Clinical Pearls for NEET-PG** * **Stage 4S Neuroblastoma:** Defined by age <1 year, localized primary, and metastasis limited to **S**kin, **S**panned liver, and **S**canty bone marrow. * **Tumor Marker:** Elevated urinary catecholamines (VMA/HVA) are seen in 90% of neuroblastomas. * **Opsoclonus-Myoclonus Syndrome:** A paraneoplastic syndrome ("dancing eyes, dancing feet") associated with favorable-prognosis neuroblastoma. * **N-myc Amplification:** The most important poor prognostic genetic marker in neuroblastoma.
Explanation: **Explanation:** Langerhans Cell Histiocytosis (LCH) is a rare proliferative disorder of myeloid dendritic cells. The correct answer is **D** because LCH is classically associated with **Exophthalmos (Proptosis)**, not enophthalmos. This occurs due to retro-orbital infiltration or bony destruction of the orbit. **Analysis of Options:** * **Option A (Peak incidence < 3 years):** This is **true**. While LCH can occur at any age, the peak incidence is between 1–3 years. Multi-system involvement is more common in infants, whereas single-system bone disease is more common in older children. * **Option B (Radiosensitive):** This is **true**. LCH lesions are highly sensitive to low-dose radiotherapy. While surgery or observation is preferred for solitary bone lesions, radiotherapy is an effective salvage treatment for lesions in critical areas (e.g., optic nerve compression). * **Option C (Letterer-Siwe disease):** This is **true**. LCH was historically categorized into three clinical syndromes: 1. **Letterer-Siwe disease:** Acute disseminated/diffuse form (infants; poor prognosis). 2. **Hand-Schüller-Christian disease:** Chronic disseminated triad of diabetes insipidus, exophthalmos, and bone lesions. 3. **Eosinophilic Granuloma:** Solitary or few bone lesions. **High-Yield Clinical Pearls for NEET-PG:** * **Pathognomonic Marker:** **Birbeck granules** (tennis-racket shaped) seen on Electron Microscopy. * **Immunohistochemistry (IHC):** Positive for **CD1a, CD207 (Langerin)**, and S100. * **Radiology:** "Punched-out" lytic lesions in the skull without a sclerotic rim. * **Commonest Site:** Bone (Skull is the most frequent site). * **Endocrine Association:** Central Diabetes Insipidus is the most common permanent endocrine complication.
Explanation: ### Explanation The clinical presentation of a 7-year-old boy with bone pain, hepatosplenomegaly, lymphadenopathy, and pancytopenia (anemia, thrombocytopenia) is classic for **Acute Lymphoblastic Leukemia (ALL)**, the most common pediatric malignancy. The bone marrow biopsy showing "scant, agranular cytoplasm and delicate chromatin" confirms the presence of lymphoblasts (L1/L2 morphology). **1. Why Option A is Correct:** * **Phenotype:** Approximately 75-80% of childhood ALL cases are of the **Early pre-B cell** lineage, which characteristically expresses **CD19**, CD10 (CALLA), and TdT. * **Karyotype:** **Hyperdiploidy** (>50 chromosomes) is the most common cytogenetic abnormality in pediatric B-ALL and is a **favorable prognostic factor**, correlating with the "complete remission" mentioned in the stem. * **Age:** The peak incidence is between 2–5 years, fitting this pediatric profile. **2. Why Other Options are Incorrect:** * **Option B:** While CD20 can be expressed in later stages of B-cell maturation, **t(9;22)** (Philadelphia chromosome) is associated with a **poor prognosis** and is more common in adults or a small subset of high-risk pediatric cases. * **Option C:** **CD5** is a T-cell marker (also found in B-CLL). ALL with T-cell markers usually presents with a mediastinal mass and higher WBC counts. * **Option D:** **CD23 and 11q deletion** are characteristic markers for **Chronic Lymphocytic Leukemia (CLL)**, which is a disease of the elderly and virtually never seen in a 7-year-old. **Clinical Pearls for NEET-PG:** * **Most common childhood cancer:** ALL. * **Good Prognosis Factors:** Age 1–9 years, WBC <50,000/µL, Hyperdiploidy, t(12;21). * **Poor Prognosis Factors:** Age <1 or >10 years, WBC >50,000/µL, Hypodiploidy, t(9;22), t(4;11). * **Common sites of relapse:** Testes and CNS (due to the blood-brain/blood-testis barrier).
Explanation: ***Acute leukemia*** - **Bone marrow blasts comprising 50%** of marrow cells confirms acute leukemia (≥20% blasts required for diagnosis). - Classic pediatric presentation with **fever**, **bleeding gums**, **fatigue**, **splenomegaly**, and **pancytopenia** (anemia, thrombocytopenia with elevated WBC count). *Infectious mononucleosis* - Typically caused by **Epstein-Barr virus** with **atypical lymphocytes** on blood smear, not blast cells. - **Bone marrow blasts** would not comprise 50% of cells; lymphadenopathy is more common than splenomegaly. *Myelofibrosis* - **Bone marrow fibrosis** leads to **dry tap** on aspiration, not cellular marrow with 50% blasts. - Characterized by **teardrop-shaped RBCs** and **leukoerythroblastic picture** on peripheral smear. *Juvenile CML* - **Chronic phase** typically shows **massive leukocytosis** (>100,000/µL) with **left shift** and **basophilia**. - **Bone marrow** shows **hypercellularity** with **<5% blasts**, not 50% as seen in this case.
Explanation: **Explanation:** The clinical presentation of a 4-year-old with petechiae, bruising, and a high leukocyte count (55,000/µL) with immature cells strongly suggests **Acute Lymphoblastic Leukemia (ALL)**, the most common pediatric malignancy. **Why Lymphoblasts are correct:** The diagnosis is confirmed by the specific cytochemical and immunophenotypic profile: * **TdT (Terminal Deoxynucleotidyl Transferase):** A hallmark marker for immature lymphocytes (both B and T cells). It is absent in myeloid cells. * **PAS (Periodic Acid-Schiff):** Characteristically shows "block-like" positivity in lymphoblasts. * **Acid Phosphatase:** Strong focal positivity in the perinuclear area is highly suggestive of **T-cell ALL**. * **MPO (Myeloperoxidase):** Negative results rule out myeloid lineage. * **Morphology:** Small, homogeneous cells with immature chromatin and indistinct nucleoli are characteristic of the **L1 subtype** (FAB classification), common in childhood ALL. **Why other options are incorrect:** * **Myeloblasts:** Would be **MPO positive** and TdT negative. They typically show Auer rods and more prominent nucleoli. * **Monoblasts:** Characteristically show **Non-specific Esterase (NSE)** positivity and are MPO negative or weakly positive. * **Megakaryoblasts:** Associated with AML-M7; they are usually negative for PAS and TdT but positive for platelet markers like CD41/CD61. **High-Yield Pearls for NEET-PG:** 1. **Most common childhood cancer:** ALL (Peak age: 2–5 years). 2. **Best Prognostic Factor:** Age 1–10 years and WBC count <50,000. 3. **Cytogenetics:** t(12;21) has a good prognosis; t(9;22) or Philadelphia chromosome has a poor prognosis. 4. **Common sites of relapse:** Testes and CNS (due to the blood-brain/blood-testis barrier).
Explanation: **Explanation:** The key to solving this question lies in the site of metastasis. **Clear Cell Sarcoma of the Kidney (CCSK)** is classically known as the **"Bone-Staining Tumor"** because of its unique propensity to metastasize to the bones—a feature rarely seen in other pediatric renal tumors. 1. **Why Option C is correct:** CCSK is the second most common malignant renal tumor in children. Unlike Wilms tumor, which primarily spreads to the lungs, CCSK has a high rate of skeletal metastasis (up to 15%). The presentation of a renal mass associated with bone pain and radiographic lytic lesions in a child is a classic "textbook" description of CCSK. 2. **Why other options are incorrect:** * **Wilms Tumor (Option A):** While it is the most common renal tumor in children, it typically metastasizes to the **lungs** (85%) and liver. Bone metastasis is extremely rare in favorable histology Wilms. * **Renal Cell Carcinoma (Option B):** RCC is rare in children (usually seen in adolescents) and typically presents with the triad of hematuria, flank pain, and a palpable mass, but it is not the most likely diagnosis in a 7-year-old with bone-only metastasis. * **Rhabdoid Tumor (Option D):** This is a highly aggressive tumor of infancy (usually <2 years old). It is characteristically associated with **Central Nervous System (CNS) tumors** (posterior fossa/rhabdoid tumors), not isolated bone metastasis. **High-Yield Clinical Pearls for NEET-PG:** * **CCSK:** Most common site of metastasis = **Bone**. * **Wilms Tumor:** Most common site of metastasis = **Lung**. * **Rhabdoid Tumor:** Associated with **Brain tumors** and carries the worst prognosis. * **Mesoblastic Nephroma:** Most common renal tumor in the **neonatal period** (benign). * **WAGR Syndrome:** Wilms tumor, Aniridia, Genitourinary anomalies, and Intellectual disability (Growth Retardation).
Leukemias
Practice Questions
Lymphomas
Practice Questions
CNS Tumors
Practice Questions
Neuroblastoma
Practice Questions
Wilms Tumor
Practice Questions
Rhabdomyosarcoma
Practice Questions
Bone Tumors
Practice Questions
Retinoblastoma
Practice Questions
Histiocytosis Syndromes
Practice Questions
Principles of Pediatric Chemotherapy
Practice Questions
Hematopoietic Stem Cell Transplantation
Practice Questions
Late Effects of Cancer Treatment
Practice Questions
Get full access to all questions, explanations, and performance tracking.
Start For Free